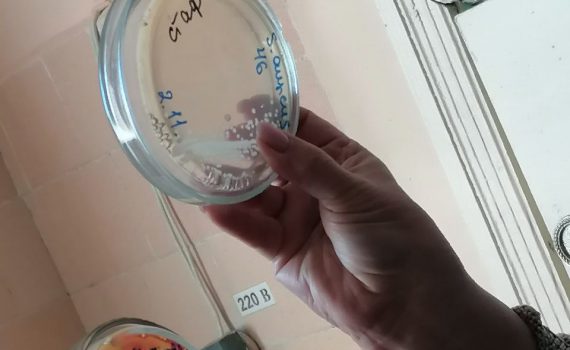

Три ГРАН-ПРИ и Лауреат 1 степени! Таков результат участия образцового хореографического коллектива «Эдельвейс» в международном конкурсе! 5 ноября образцовый хореографический коллектив «Эдельвейс» (руководители Ольга Никитина […]
Архивы по дням: 08.11.2023
Ребят встретила Ланина Лариса Борисовна, главный врач Филиал ФБУЗ «Центр гигиены и эпидемиологии в Тамбовской области» в городе Рассказово, городе Кирсанове, Рассказовском, Кирсановском, Гавриловском, Уметском […]
10 октября был дан старт третьему творческому конкурсу памяти народного артиста СССР, Героя Труда РФ, сопредседателя Центрального штаба Бессмертного полка России Василия Ланового «Пробуждая сердца». Конкурс уже […]
Основная задача Конференции – создание эффективных механизмов развития патриотического, духовно-нравственного, и художественно-эстетического воспитания детей и молодёжи средствами кино, анимации и мультимедиа через формирование понимания культурного […]
В филиале МБОУ «Ржаксинская СОШ №1 им. Н.М. Фролова» в п. Чакино в рамках работы кружка МиРоботов были собраны и запрограммированы Автоматизированные часы. Органично сконструированные […]
С 27 октября по 6 ноября 2023 года в пос. Красные ткачи, пригороде г. Ярославля, проходило первенство Центрального федерального округа (ЦФО) среди мальчиков и девочек […]
БОЛЬШОЙ ФИНАЛ! Победителей Всероссийского конкурса «Большая перемена» наградили в «Артеке»! Дарья Кувшинова – активист Движения Первых города Мичуринска стала победителем в вызове «Делай Добро!»; Алина […]
Приглашаем принять участие в новом проекте — «ПЕРВЫЕ в журнале «Агрегатор счастья»», при поддержке Российского движения детей и молодежи «Движение Первых», в рамках которого планируются следующие мероприятия: […]
2 ноября команда юных шахматистов Центра детского творчества приняла участие в Открытом первенстве города Мичуринска по шахматам. Шахматный турнир, который проводил Центр развития современных компетенций […]
4 ноября в г. Тамбове состоялись Открытый ковер по рукопашному бою среди мальчиков и девочек 8-9, 10-11 лет и Открытый областной турнир «Юный динамовец» среди […]